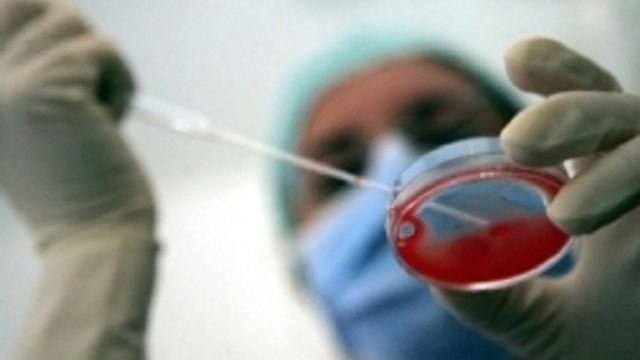

Ricostruire un cuore partendo da un lembo di pelle. Dare nuova vita a organi debilitati o inservibili dopo una malattia. Non uno scenario fantascientifico, ma un possibile futuro sviluppo di una ricerca coordinata dall'Università di Pittsburgh. Dopo aver spogliato un cuore di un topo dalle sue cellule, i ricercatori lo hanno infatti ricostruito, partendo solo dallo "scheletro" dell'organo stesso e utilizzando cellule da lembi di pelle umana.
Per la prima volta il cuore di un topo è tornato quindi a battere dopo essere stato "decellularizzato", questo il nome della tecnica, come riporta "Nature Communication". Il successo ottenuto dal gruppo di ricerca mostra le potenzialità della rigenerazione "personalizzata" degli organi.
La tecnica di "decellularizzazione" - Mettendo a punto una complessa tecnica "decellularizzante", i ricercatori statunitensi sono riusciti a spogliare il cuore di un topo da tutte le sue cellule funzionali lasciando intatta la sua "impalcatura". Dopo averlo quindi "pulito", hanno quindi ripopolato questo "scheletro" con cellule umane progenitrici dei tessuti cardiovascolari.
Queste cellule erano state ottenute trattando un gruppo di staminali umane pluripotenti indotte (iPSC), ovvero cellule adulte già specializzate riprogrammate per tornare "bambine", prelevate da una piccola porzione di pelle. Dopo poche settimane il cuore non solo si è rigenerato con cellule umane ma è tornato a battere con una frequenza di circa 40/50 battiti al minuto.
"In futuro potremo riparare e ricostruire qualsiasi tipo di organo" - Molto lavoro, hanno spiegato i ricercatori, deve ancora essere fatto affinché la tecnica possa portare alla realizzazione di un organo realmente efficiente eppure la tecnica mostra le grandi potenzialità della rigenerazione degli organi. "Il nostro prossimo obiettivo - ha spiegato Lei Yang, uno dei responsabili della ricerca - è quello di capire la fattibilità di creare "toppe" per riparare il muscolo cardiaco umano e riparare le aree danneggiate da un infarto". In futuro, spiegano ancora i ricercatori, potrebbe essere possibile prendere un piccolo campione di pelle da un paziente e ricostruire su impalcature biologiche qualsiasi tipo di organo da trapiantare.